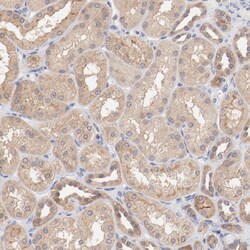
Invitrogen SETD3 Polyclonal Antibody 100 &mu;L; Unconjugated:Antibodies,

missing translation for 'onlineSavingsMsg'
Learn More
Learn More
Invitrogen™ SETD3 Polyclonal Antibody


Rabbit Polyclonal Antibody
Brand: Invitrogen™ PA582111
This item is not returnable.
View return policy
Description
Immunogen sequence: SGTGATATVS PKEILNLTSE LLQKCSSPAP GPGKEWEEYV QIRTLVEKIR KKQKGLSVTF DGKREDYFPD LMKWASENGA SVEGFEMVNF KEEGFGLRAT RDIKAEELFL WVPRKLLMTV E Highest antigen sequence indentity to the following orthologs: Mouse - 98%, Rat - 98%.
SETD3 is a histone methyltransferase that is involved in epigenetic transcriptional activation by methylating lysine residues on histone H3 tails.
Specifications
| SETD3 | |
| Polyclonal | |
| Unconjugated | |
| SETD3 | |
| 2610102I01Rik; 2610305M23Rik; 4921524K10Rik; 6030490B17Rik; Actin-histidine N-methyltransferase; BC031601; C14orf154; D12Ertd771e; Endothelial differentiation inhibitory protein D10; histone-lysine N-methyltransferase SETD2; histone-lysine N-methyltransferase setd3; hSETD3; Kiaa1732; KMT3A; Lysine N-methyltransferase 3A; Protein-lysine N-methyltransferase SETD2; RGD1309550; SET domain containing 2; SET domain containing 3; SET domain-containing protein 2; SET domain-containing protein 3; Setd2; Setd3 | |
| Rabbit | |
| Antigen affinity chromatography | |
| RUO | |
| 84193 | |
| Store at 4°C short term. For long term storage, store at -20°C, avoiding freeze/thaw cycles. | |
| Liquid |
| Immunohistochemistry (Paraffin), Western Blot | |
| 0.1 mg/mL | |
| PBS with 40% glycerol and 0.02% sodium azide; pH 7.2 | |
| Q86TU7 | |
| SETD3 | |
| Recombinant protein corresponding to Human SETD3. Recombinant protein control fragment (Product #RP-89072). | |
| 100 μL | |
| Primary | |
| Human | |
| Antibody | |
| IgG |
Product Content Correction
Your input is important to us. Please complete this form to provide feedback related to the content on this product.
Product Title
Spot an opportunity for improvement?Share a Content Correction